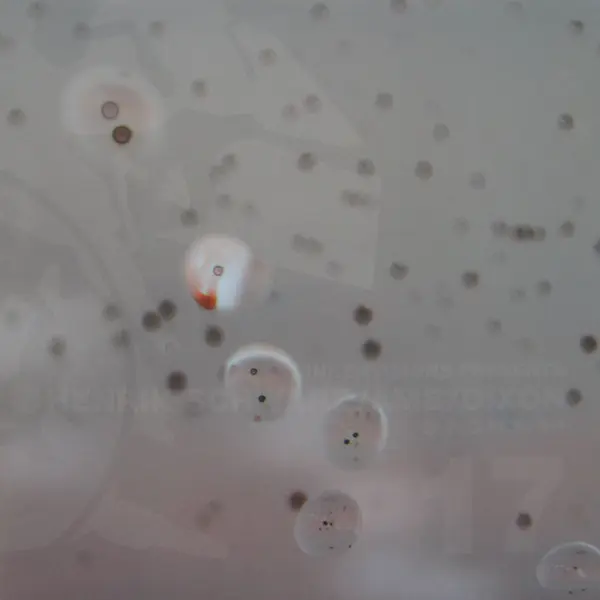
D.P.O.M.B. EP

Loading...



Innervisions
3 releases
| PRICE | Image | Title | Artist | Genre | Style | Label | Year | Country | Format | Condition | Comment | |
|---|---|---|---|---|---|---|---|---|---|---|---|---|
| $20 |
| D.P.O.M.B. EP | Henrik Schwarz / Âme / Dixon | Electronic | Deep House, Techno | Innervisions | 2008 | Germany | 1 x 12", EP, 45 RPM, 33 ⅓ RPM | VG+ | ||
| $20 |

| Sleepy Hollow EP | Stefan Goldmann | Electronic | Minimal, Tech House | Innervisions | 2006 | Germany | 1 x 12", EP, 45 RPM | NM- | ||
| $20 |

| Anton's Groove EP | Toni Rantanen | Electronic | House, Tech House, Techno | Innervisions | 2011 | Germany | 1 x 12", EP, 45 RPM, 33 ⅓ RPM | VG+ |
1-0 of 0
